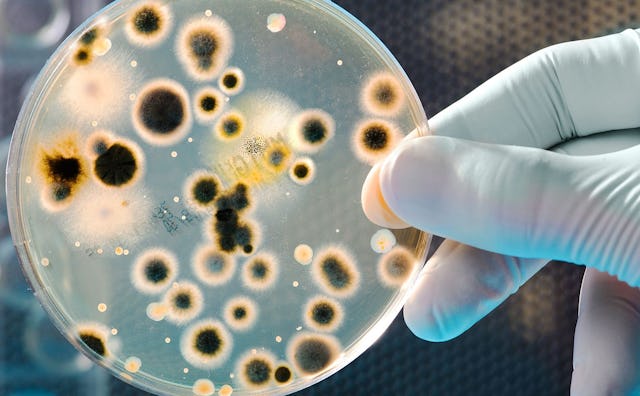

High School Preaches Abstinence, Has Big Chlamydia Outbreak
Of course we know that if 1 in 15 students in the school have chlamydia, many more of them are having sex—it’s just a numbers thing. No matter what any parent or state lawmaker’s beliefs are, teens are going to have sex. As their guiding mentors, teachers and parents alike have a duty to tell them how to do it responsibly. If they can’t learn from us, they’ll try to learn from something else. Maybe they’ll try to learn from porn, which I’ll just straight up call a little misleading.
The murky definitions of sex that pop up among teens who are remaining “abstinent” might be part of the problem here. Chlamydia can be transmitted through oral and anal sex. As you might have read via Dan Savage and other sources, these are sometimes considered to be technically not sex to teens eager to have sex and simultaneously retain their virginity label. And if that sounds crazy, consider for a moment something way crazier: An entire high school is refusing to teach sex ed, but is sending out letters to parents about a chlamydia outbreak.
This article was originally published on